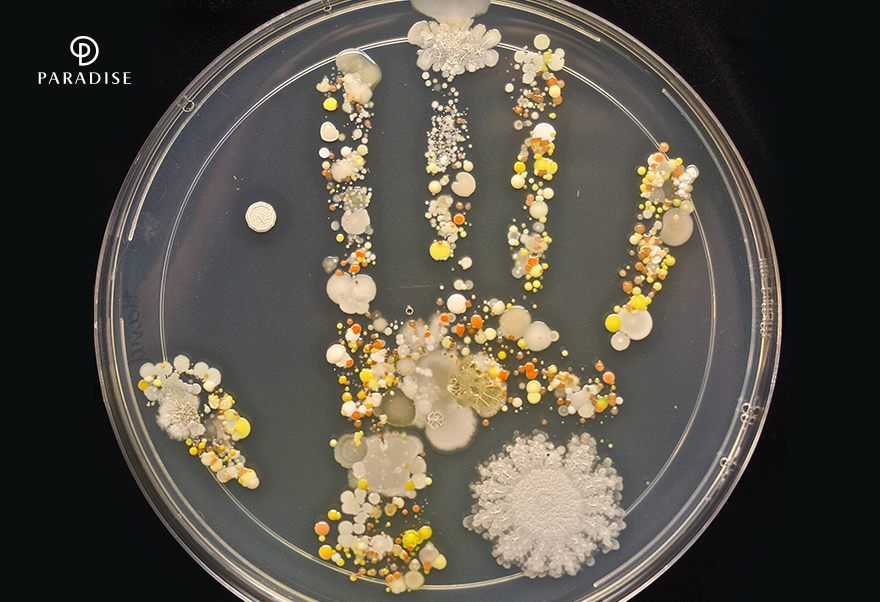

새로운 영감이 가득한 축제의 서막,
2022 파라다이스 아트랩 페스티벌 <오픈 톡 OPEN TALK> 개최

파라다이스 문화재단이 주최하는 2022 파라다이스 아트랩 페스티벌의 서막이 올랐습니다. 지난 3월 24일, 파라다이스 시티에서 올해의 참여 아티스트들의 첫 대면식인 <오픈 톡 Open Talk>이 개최된 것인데요. 이번 행사에는 지난해 10월 엄격하고 공정한 심사를 통해 선정된 다양한 분야의 아티스트, 파라다이스 문화재단, 파트너사가 한자리에 모였습니다. 첫 인사를 건넨 이들은 선정된 작품 소개와 함께 구체적인 페스티벌 계획을 공유하며 편안한 이야기를 나누는 시간을 가졌습니다.
올해로 3회째를 맞이하는 파라다이스 아트랩은 동시대 예술 흐름을 반영한 창ᆞ제작 지원사업입니다. 작품 공모를 시작으로 1년여의 작품 선정과 제작 과정을 진행한 후 쇼케이스를 통해 작품을 선보이죠. 2022 파라다이스 아트랩 페스티벌은 다가오는 5월 파라다이스시티에서 만나볼 수 있습니다. 이번 파라다이스 아트랩이 어떤 새로운 자극과 영감을 불어넣을지 많은 기대와 관심 부탁드립니다.
비노파라다이스, 대한민국 주류대상에서
‘베스트 오브 2022’ 및 대상 수상의 영예

비노파라다이스가 국내 최고의 주류를 가리는 ‘2022 대한민국 주류대상’에서 올해 최고의 수상작인 ‘베스트 오브 2022’는 물론, 총 13개의 와인으로 각 부문 대상을 수상했습니다. 올해로 9회를 맞이하는 대한민국 주류대상에는 역대 최대 규모인 812개의 브랜드가 참여했는데요. 코로나와 함께 집에서 와인을 즐기는 ‘홈술족’이 늘어남에 따라 와인 시장이 급성장하면서 특히 와인 부문의 경쟁이 치열했죠.

‘베스트 오브 2022’는 부문별 최고의 점수를 받은 와인으로 로제와인 부문에서 ‘스프링 시드 모닝 브라이드 로제’가 그 수상의 영예를 안았습니다. 이 외에도 비노파라다이스의 13종의 와인들이 와인 8개 부문 중 6개 부문에서 대상을 수상하며 그 위상을 입증했는데요. 전문가들의 까다로운 심사를 거쳐 선정된 비노파라다이스의 수상 와인 13종을 확인하고 품격 있는 맛을 경험해보세요.
※비노파라다이스 와인 구매 Info.
- 정보: 홈페이지 바로 가기
- 구매 문의: 02-2280-5286
파라다이스시티에서 즐기는
다채롭고 특별한 엔터테인먼트

파라다이스시티에서만 만날 수 있는 고객맞이 엔터테인먼트가 더욱 새롭고 풍성해졌습니다. 방문 고객의 눈과 귀를 사로잡으며 특별한 경험을 선사하는 다채로운 그리팅 프로그램을 소개합니다.
파라다이스시티 호텔 1층 쿠사마 야요이의 작품이 자리잡은 ‘와우존’에는 파라다이스시티만의 가면무도회 ‘마스커레이드 쇼’가 진행됩니다. 베네치아 카니발을 연상케 하는 의상을 입은 퍼포머들이 호박 작품 주위를 돌며 모두의 시선을 사로잡습니다. 라이브로 연주되는 바이올린 선율과 우아한 춤 동작이 어우러져 환상적인 분위기를 자아내죠. 호텔을 지나 ‘플라자’에 다다르면 흥겨운 유러피안 유랑단의 무대가 펼쳐집니다. 서커스, 마술, 댄스가 결합된 다채로운 무대로 색다른 경험을 선사합니다.

한편, ‘원더박스’에서는 밤의 유원지를 연상시키는 화려한 카니발을 만날 수 있습니다. 카니발 퍼레이드의 시작과 함께 원더박스 전체가 무대로 변신하는데요. 광대분장을 한 퍼포머들이 이끄는 퍼레이드는 관객이 함께 참여해 원더박스를 거닐며 신나는 포토타임도 즐길 수 있습니다. 축제 분위기를 한층 높여줄 ‘매직 서커스’ 무대도 빼놓을 수 없는데요. 일루전 매직, 플라잉 박스, LED 저글링이 결합된 개성 넘치는 퍼포먼스들로 구성되어 있습니다. 더불어, 원더박스에서의 소중한 순간을 캐리커처로 남길 수 있는 이벤트도 놓칠 수 없는 즐거움이죠.
다양한 퍼포먼스가 가득한 파라다이스시티를 방문할 예정이라면 프로그램 별 일정을 확인한 후 특별한 엔터테인먼트와 함께 소중한 추억을 남겨보세요.
동영상 서비스가 종료되어 해당 콘텐츠를 재생할 수 없습니다.
※파라다이스시티 페스티벌 Info.
- 정보: 홈페이지 바로 가기
- 장소: 이벤트별 상이 (자세한 일정과 장소는 정보란의 ‘홈페이지 바로가기’를 참조해 주세요.)
| <오후 5시에 쏟아지는 깜짝 퀴즈> 4월 사보 이벤트 (8) | 2022.04.12 |
|---|---|
| 진심을 담은 열정으로 고객만족 실현, 파라다이스그룹의 우수 사원을 만나다 (7) | 2022.04.05 |
| 파라다이스 그룹 3월 블로그 이벤트 5회차 당첨자 발표 (0) | 2022.03.28 |
| 파라다이스 그룹 3월 블로그 이벤트 (5회차) & 4회차 당첨자 발표 (34) | 2022.03.25 |
| 파라다이스 그룹 3월 블로그 이벤트 (4회차) & 3회차 당첨자 발표 (44) | 2022.03.24 |
댓글 영역